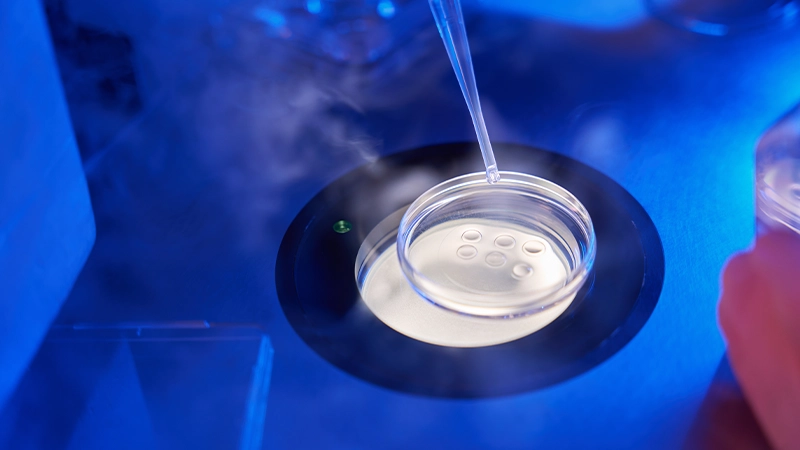
Hidrojel Enjeksiyonu Sonrası İyileşme Süreci Nasıldır?

Yeni Nesil Hidrojel (Poliakrilamid Hidrojel) Nedir?
“Yeni Nesil Hidrojel” Diz kireçlenmesi, günlük yaşam kalitesini olumsuz etkileyen yaygın bir eklem rahatsızlığıdır. Geleneksel tedavi yöntemlerinin yanı sıra, yeni nesil hidrojel (poliakrilamid hidrojel) uygulamaları da giderek popülerleşmektedir. Peki, hidrojel nedir ve diz kireçlenmesi tedavisinde nasıl bir rol oynar? Bu makalede, hidrojel tedavisi hakkında merak edilen tüm sorulara yanıt bulacaksınız.
İçindekiler
- Hidrojel Tedavisi Diz Kireçlenmesinde Nasıl Etki Gösterir?
- Poliakrilamid Hidrojel Uygulaması Kimler İçin Uygundur?
- Hidrojel Enjeksiyonu Sonrası İyileşme Süreci Nasıldır?
- Diz Kireçlenmesinde Hidrojel Tedavisinin Avantajları Nelerdir?
- Hidrojel Tedavisi Güvenli mi? Yan Etkileri Var mı?
- Hidrojel ile Diz Protezi Arasındaki Farklar Nelerdir?
- Hidrojel Tedavisinin Etkinliği Ne Kadar Süre Devam Eder?
- Sıkça Sorulan Sorular
- Sonuç ve İletişim
Hidrojel Tedavisi Diz Kireçlenmesinde Nasıl Etki Gösterir?
Hidrojel, su tutma kapasitesi yüksek olan polimerik bir maddedir. Poliakrilamid hidrojel, bu maddelerin en yeni nesil temsilcisidir. Diz eklemine enjekte edildiğinde, hidrojel eklem boşluğunda kayganlaştırıcı bir etki yaratır ve kıkırdak yüzeylerin rahatça hareket etmesini sağlar. Ayrıca, basıncı azaltarak ağrının hafiflemesine yardımcı olur.
Hidrojelin temel işlevi, eklem içindeki sinovyal sıvının yerini alarak eklem yüzeylerini korumaktır. Bu sayede, kıkırdak hasarının ilerlemesi yavaşlar ve eklem hareketliliği artar. Özellikle diz kireçlenmesi olan hastalarda, hidrojel tedavisi günlük aktivitelerin daha rahat yapılmasını sağlar.
Poliakrilamid Hidrojel Uygulaması Kimler İçin Uygundur?
Poliakrilamid hidrojel uygulaması, özellikle erken ve orta evre diz kireçlenmesi olan hastalar için idealdir. Eğer cerrahi müdahaleye gerek kalmadan ağrılarınızı hafifletmek ve yaşam kalitenizi yükseltmek istiyorsanız, bu tedavi sizin için uygun olabilmektedir.
Aşağıdaki durumlarda hidrojel tedavisi düşünülebilmektedir:
- Dizde kronik ağrı ve sertlik
- İlaç tedavilerine rağmen ağrının devam etmesi
- Fizik tedavi yöntemlerinden fayda görülmemesi
- Cerrahi risklerin yüksek olması veya cerrahiyi istememe
Ancak, ileri derece kireçlenme ve eklem deformiteleri olan hastalarda hidrojel tedavisi yeterli olmayabilmektedir. Bu nedenle, doğru tedavi seçeneği için bir ortopedi uzmanına danışmanız önemlidir.
Hidrojel Enjeksiyonu Sonrası İyileşme Süreci Nasıldır?
Hidrojel enjeksiyonu, genellikle ayaktan uygulanan ve kısa süren bir prosedürdür. İşlem sonrasında hastalar hemen günlük aktivitelerine dönebilirler. Ancak, enjeksiyon bölgesinde hafif şişlik ve hassasiyet oluşabilmektedir. Bu belirtiler genellikle birkaç gün içinde kendiliğinden geçer.
İyileşme sürecinde dikkat edilmesi gerekenler:
- İlk 24 saat ağır fiziksel aktivitelerden kaçının.
- Enjeksiyon bölgesini temiz ve kuru tutun.
- Doktorunuzun önerdiği ağrı kesicileri kullanabilirsiniz.
- Kontrol randevularınızı aksatmayın.
İlk haftalardan itibaren ağrılarınızın azaldığını ve hareket kabiliyetinizin arttığını fark edeceksiniz. Tam etkinin ortaya çıkması birkaç hafta sürebilmektedir.
Diz Kireçlenmesinde Hidrojel Tedavisinin Avantajları Nelerdir?
Hidrojel tedavisinin diz kireçlenmesi üzerinde birçok avantajı bulunmaktadır:
- Non-invaziv Bir Yöntemdir: Cerrahi müdahaleye gerek kalmadan uygulanır.
- Hızlı İyileşme Sağlar: Hastalar işlem sonrası hemen günlük yaşamlarına dönebilirler.
- Ağrıyı Azaltır: Eklem içindeki sürtünmeyi azaltarak ağrıyı hafifletir.
- Hareket Kabiliyetini Artırır: Eklemdeki sertliği azaltarak hareketliliği artırır.
- Güvenlidir: Yan etki riski düşüktür ve alerjik reaksiyonlara nadiren neden olur.
Bu avantajlar sayesinde, hidrojel tedavisi diz kireçlenmesi olan hastalar için etkili bir alternatif oluşturmaktadır.

Hidrojel Tedavisi Güvenli mi? Yan Etkileri Var mı?
Hidrojel tedavisi, yıllardır güvenle kullanılan bir yöntemdir. Poliakrilamid hidrojel, biyouyumlu bir madde olduğu için vücut tarafından iyi tolere edilebilmektedir. Yan etkiler genellikle minimaldir ve kısa sürelidir.
Olası yan etkiler şunlardır:
- Enjeksiyon bölgesinde hafif ağrı veya şişlik
- Geçici hassasiyet
- Nadir durumlarda enfeksiyon riski
Bu yan etkiler genellikle basit önlemlerle kontrol altına alınabilmektedir. Tedavinin güvenliği için işlemin deneyimli bir ortopedi uzmanı tarafından yapılması önemlidir.
Hidrojel ile Diz Protezi Arasındaki Farklar Nelerdir?
Hidrojel tedavisi ve diz protezi, diz kireçlenmesinde kullanılan iki farklı yaklaşımdır. Aralarındaki temel farklar şunlardır:
- İnvazivlik: Hidrojel enjeksiyonu minimal invaziv bir işlemdir, diz protezi ise cerrahi bir müdahaledir.
- İyileşme Süresi: Hidrojel sonrası iyileşme hızlıdır, protez ameliyatı sonrası ise daha uzun bir rehabilitasyon süreci gerekir.
- Riskler: Hidrojel tedavisinin riskleri düşüktür, protez ameliyatı ise daha yüksek komplikasyon riskine sahiptir.
Tedavi seçimi, hastanın yaşı, kireçlenme derecesi ve genel sağlık durumuna bağlıdır. En uygun seçenek için doktorunuzla detaylı bir şekilde görüşmelisiniz.
Hidrojel Tedavisinin Etkinliği Ne Kadar Süre Devam Eder?
Hidrojel tedavisinin etkinliği hastadan hastaya değişmekle birlikte, genellikle uzun yıllar sürer. Bu süre zarfında ağrılarınız azalır ve hareket kabiliyetiniz artar. Etkinlik süresi sonunda, gerekirse tedavi tekrarlanabilmektedir.
Tedavinin kalıcılığını etkileyen faktörler:
- Hastanın yaşı ve genel sağlık durumu
- Kireçlenmenin derecesi
- Fiziksel aktivite seviyesi
- Doktorun önerilerine uyum
Düzenli kontroller ve uygun yaşam tarzı değişiklikleri ile tedavinin etkinliği artırılabilmektedir.

Sıkça Sorulan Sorular
Hidrojel enjeksiyonu sırasında lokal anestezi uygulanır, bu nedenle işlem sırasında ağrı hissetmezsiniz. İşlem sonrasında hafif bir rahatsızlık olabilmektedir, ancak bu genellikle kısa sürelidir.
Genellikle hafif egzersizlere ve sporlara 1-2 hafta içinde dönebilirsiniz. Ancak, doktorunuzun önerilerine uymanız önemlidir.
Evet, ancak en iyi sonuçlar genellikle erken ve orta evre kireçlenmesi olan hastalarda görülmektedir. İleri yaşta ve ileri derecede kireçlenmesi olan hastalarda etkinlik azalabilmektedir.
Evet, hidrojel tedavisi diz dışında kalça, omuz ve ayak bileği gibi diğer eklemlerde de kullanılabilmektedir.
Yan etkiler genellikle minimaldir ve enjeksiyon bölgesinde hafif ağrı, şişlik veya kızarıklık şeklinde görülmektedir. Nadir durumlarda enfeksiyon riski vardır.
Hidrojel tedavisi eklemde kayganlık sağlayan bir madde enjekte ederken, PRP tedavisi hastanın kendi kanından elde edilen büyüme faktörlerini kullanır. İki tedavi farklı mekanizmalarla etki gösterir.
Genellikle fizik tedaviye ihtiyaç duyulmaz, ancak bazı durumlarda doktorunuz hareket kabiliyetini artırmak için egzersizler önerebilmektedir.
Hamilelik sırasında hidrojel tedavisi genellikle önerilmemektedir. Bu konuda doktorunuza danışmanız gerekir.
Sağlıklı bir beslenme, eklem sağlığı için faydalıdır. Özellikle anti-inflamatuar gıdalar tüketmek iyileşme sürecini destekleyebilir.
Doktorunuzun önerilerine uymak, düzenli egzersiz yapmak ve ideal kilonuzu korumak tedavinin etkinliğini artırabilir.

Sonuç ve İletişim
Diz kireçlenmesi yaşam kalitenizi düşürüyorsa, yeni nesil hidrojel tedavisi sizin için etkili bir çözüm olabilir. Hem güvenli hem de hızlı iyileşme sağlayan bu yöntemle ağrılarınızı hafifletebilir ve hareket kabiliyetinizi artırabilirsiniz.
Daha detaylı bilgi ve randevu almak için uzman hekiminizle iletişime geçebilirsiniz.
Not: Bu makale bilgilendirme amaçlıdır ve tedavi önerisi niteliği taşımaz. Sağlığınızla ilgili kararları mutlaka doktorunuza danışarak almalısınız.